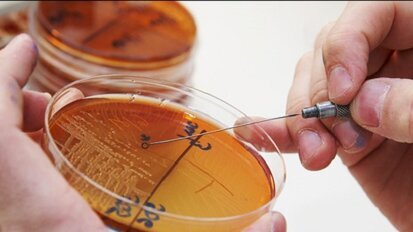
Καρκίνος κεφαλής και τράχηλου. Νέο σύστημα απλοποιεί τον θεραπευτικό σχεδιασμό

-
 Αυστρία / Österreich
Αυστρία / Österreich
-
 Βοσνία και Ερζεγοβίνη / Босна и Херцеговина
Βοσνία και Ερζεγοβίνη / Босна и Херцеговина
-
 Βουλγαρία / България
Βουλγαρία / България
-
 Κροατία / Hrvatska
Κροατία / Hrvatska
-
 Τσεχία & Σλοβακία / Česká republika & Slovensko
Τσεχία & Σλοβακία / Česká republika & Slovensko
-
 Γαλλία / France
Γαλλία / France
-
 Γερμανία / Deutschland
Γερμανία / Deutschland
-
 Ελλάδα / ΕΛΛΑΔΑ
Ελλάδα / ΕΛΛΑΔΑ
-
 Ουγγαρία / Hungary
Ουγγαρία / Hungary
-
 Ιταλία / Italia
Ιταλία / Italia
-
 Ολλανδία / Nederland
Ολλανδία / Nederland
-
 Σκανδιναβικές χώρες / Nordic
Σκανδιναβικές χώρες / Nordic
-
 Πολωνία / Polska
Πολωνία / Polska
-
 Πορτογαλία / Portugal
Πορτογαλία / Portugal
-
 Ρουμανία & Μολδαβία / România & Moldova
Ρουμανία & Μολδαβία / România & Moldova
-
 Σλοβενία / Slovenija
Σλοβενία / Slovenija
-
 Σερβία & Μαυροβούνιο / Србија и Црна Гора
Σερβία & Μαυροβούνιο / Србија и Црна Гора
-
 Ισπανία / España
Ισπανία / España
-
 Ελβετία / Schweiz
Ελβετία / Schweiz
-
 Τουρκία / Türkiye
Τουρκία / Türkiye
-
 Ηνωμένο Βασίλειο & Ιρλανδία / UK & Ireland
Ηνωμένο Βασίλειο & Ιρλανδία / UK & Ireland
 Διεθνές / International
Διεθνές / International
 Βραζιλία / Brasil
Βραζιλία / Brasil
 Καναδάς / Canada
Καναδάς / Canada
 Λατινική Αμερική / Latinoamérica
Λατινική Αμερική / Latinoamérica
 Η.Π.Α. / USA
Η.Π.Α. / USA
 Κίνα / 中国
Κίνα / 中国
 Ινδία / भारत गणराज्य
Ινδία / भारत गणराज्य
 Πακιστάν / Pākistān
Πακιστάν / Pākistān
 Βιετνάμ / Việt Nam
Βιετνάμ / Việt Nam
 ASEAN / ASEAN
ASEAN / ASEAN
 Ισραήλ / מְדִינַת יִשְׂרָאֵל
Ισραήλ / מְדִינַת יִשְׂרָאֵל
 Αλγερία, Μαρόκο & Τυνησία / الجزائر والمغرب وتونس
Αλγερία, Μαρόκο & Τυνησία / الجزائر والمغرب وتونس
 Μέση Ανατολή / Middle East
Μέση Ανατολή / Middle East